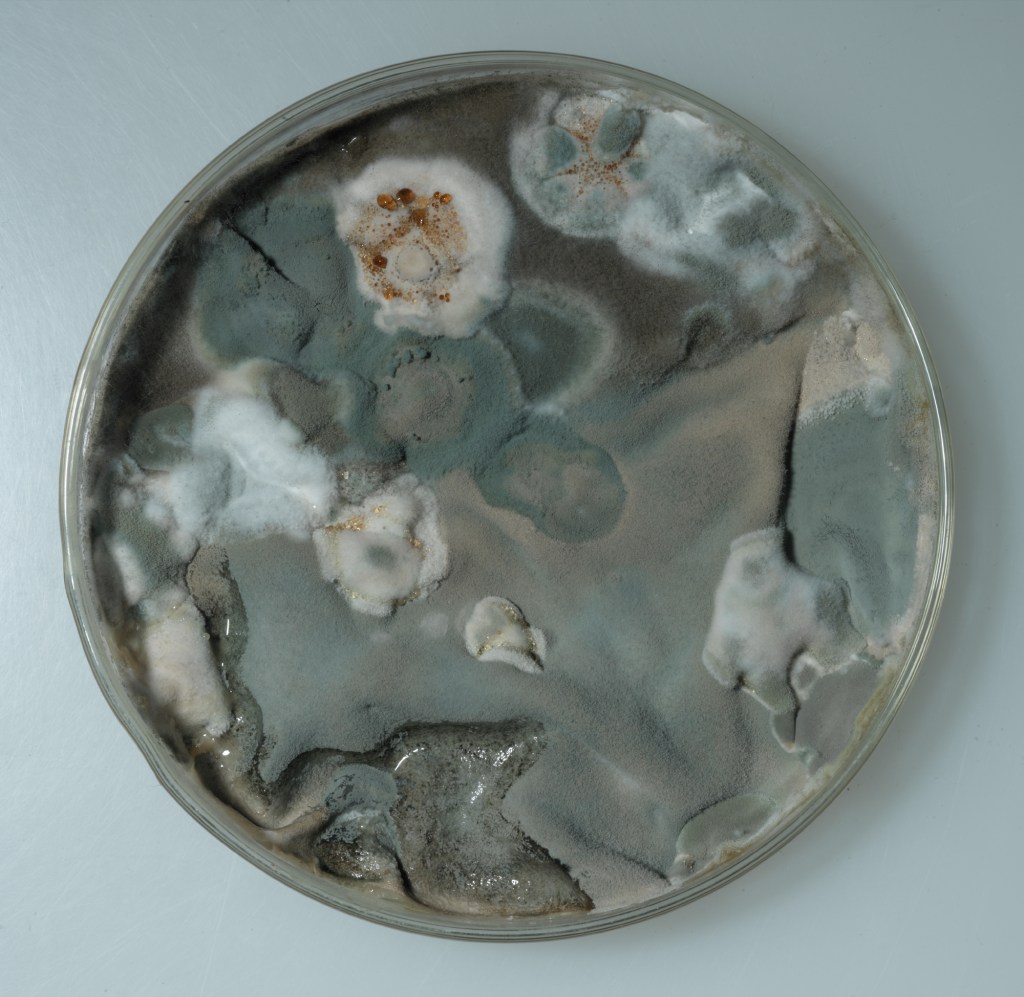

- What do you do? What sort of things do you make? Or select?
Much of my artwork to date has been object-oriented and large scale; ordered assemblages of smaller scale bespoke units. My artworks have at their core the same central themes, but in each new artefact or iteration certain distinct thought processes have occurred and new connections fused. Thus, ever-expanding tangental thematic branches radiate outwards, much like unobserved mycelial root systems.
My previous artworks are primarily concerned with ideas relating to preservation vs. decay, museum policies and practices, and the concept of ‘still life’. Certain aspects of these themes still engage me; institutional structures and the value systems contained therein, what is chosen to be preserved, valued, displayed; what is chosen to be representative of its kind. I am also intrigued by the notion of ‘essence’, both as relating to life force ( or lack of it) and what it is that actually defines or makes something intrinsically itself.
- What is it that you’ve been trying to do to make the work relevant in relation to ideas, cultural circumstances or contemporary issues?
I am currently drawn to the issues of authorship and ownership, specifically of Art, and the moral, ethical and legal considerations thereof.
The question of ownership, especially of land and museological artefacts, is a fairly recent ecumenical quandary. The history of European colonial expansion, with its ethnological and environmental consequences is only now being confronted. Recently, certain esteemed Art institutes have been lobbied to reject unsavoury sponsorship liaisons and Governments persuaded to return significant indigenous treasures to their places of origin. Authenticity and accountability are at last gaining some traction.
The COVID-19 pandemic has brought a new awareness of both our global interconnectedness and our inherent precarity. As human beings subsisting through this unprecedented period, we are brought face to face with our essential biological nature as we confront the collective hubris of our purported ‘management’ of the natural world.
In using bacteria as both medium and subject matter within my artwork, I will need to be aware of these associations and the connotations they invoke.
- How do you make decisions during the course of your work? How and why do you select the materials, techniques, themes that you do?
It is important to me that the ideas, materials and processes all inter-relate. Each carry ingrained meanings and histories which inform the other. For example, my earlier works are based upon a photograph I took of a mouldy wooden beam in Tibet.

Abbie Read, Decayed wooden beam. [Photographic print]. 1999
By taking a photo of a piece of rotten wood, I am in effect halting the process of decay, and preserving its form. Repainting this image onto a wooden canvas in layers re-enacts this process in reverse; an inverse entropy. In the act of repainting, the original beam is regenerated and preserved once again. It is this ‘stop-start’ paradox of the notion of ’still life’ which I find appealing. It is an entirely oxymoronic concept: Life cannot, by definition, be still. Yet it is a prevalent art historical paradigm and an unavoidable consequence in archetypal exhibition practices exemplified in the museological vitrine.
- Why have you created the work you exhibited at seminar and what is its history?
During the February seminar, I exhibited a photograph that relates to the following artwork:

Abbie Read, Vitreus Mundi. [Photographic print of bacteria. 800mm]. 2005
The organic seductive textures resembling fluffy hillocks on velvet landscapes initially belie its veracity as a bacterial colony. Its circular form and ostensibly ‘glass-encased’ setting reference the omnipotent genesis of life as demonstrated in both petri-dish, by scientist and in glass frame by artist. It re-enacts the role of the sacrosanct vitrine; the reliquary of the museological world, and of the contextual time capsule, here as incubator for fledgling life.
- What are you trying to say in the work? What are you valuing in the work?How is the way you are saying it, with the materials, techniques and themes, the best for the idea you want to present?
This microbial terra firma is intended to captivate the viewer from afar, to seduce and thus conversely pre-empt the antithetical repugnance afforded by a later realisation of its true subject matter. Whether seen as a visual treaty on colonisation both bacterial and global, or more literally as a circular porthole; a window on life, it alludes to the cyclical nature of all things and all processes. However, my main aim was to examine the performance art of creation; the generative act of the artist. The creation as manifested in this artwork is in the growing of the life forms themselves. The photography, be it beautifully executed, is here utilised as documentation only; in the capturing of the frozen moment and the stilling of life once more. By reconstituting the photograph as sculptural art piece, the object is given new form, a new incarnation, a new life. Ultimately, the viewer’s interaction with the pieces breathes life into it anew.
A photograph is a momentary evidential record, an arbitrary hesitation on an otherwise progressive continuum. If a photograph represents truth, it is a truth of a moment only.
- How does your current work relate to your previous work?
Currently I am exploring decay both naturally occurring and enforced. Using clay, soil, and gold to navigate implicit value systems. In Japanese culture, a seemingly ‘worthless’ broken object is given new life and value through the application of care, craftsmanship, time and the addition of costly precious metal, usually gold. The ancient tradition of Kintsugi exemplifies the philosophy of wabi-sabi – the embracing of imperfection. This speaks to my central themes of preservation vs. decay.
- What influences your work?
For me, it is the ideas that are paramount to the propagation of the work. These may be invoked, enhanced or challenged by any books, films, articles or exhibitions I have recently encountered. I am excited about my own work only when several of the concepts or themes I have been carrying coalesce and unify. At this point, I mentally audition materials and processes which might best explore or express these ideas.
Certain landmark artworks I have encountered over the years have been instrumental in shaping my practice. One such work is Michael Landy’s performative installation Break Down 2001, in which he individually destroyed every item that he currently owned. Such an all encompassing undertaking, I find it a remarkable work in so many respects; each documented category of possessions (photographs, official documentation, money) laden with consequential significance. But it is one particular category and pertinent fact which haunts me: he destroyed other artists’ artworks as well as his own.
Is that legally, morally or ethically acceptable? Is art ever really ‘owned’? Or are prospective buyers merely posterity’s de facto caretakers? Was Duchamp justified in painting a moustache on a reproduction of the Mona Lisa or the Chapman brothers when altering a set of Goya’s etched prints? Can the act of vandalism be considered art? At what point does a copy or a parody become art in its own right?
I have taken these themes into my ongoing practice, and am currently exploring matters of solicited or unsolicited collaboration and destruction as an act of creation. Essentially I am interested in the issues of authorship, ownership, identity and hierarchy as they relate to art; legally, morally and ethically.
- What are your sources or inspirations for images or forms used?
I am interested in generative and de-generative systems such as: mould, rust, bacteria, dust, osteoporosis and erosion, both as artistic medium or process and for their inherent physiological associations.
These are organisms and processes not usually deigned either valuable or beautiful, yet taken out of their more mundane contexts, these qualities can be reevaluated and ascribed.
- How does this work fit into a larger body of work or overarching project of ideas (if it does)?
I see each artwork as a component part of that which will one day comprise an entire anthology; a museum in and of itself: a storehouse of its own histories and iterations.
Each work is analogous to the whole and helps reveal diverse yet complimentary nuances when seen in relation to each other.
- How did your ideas change (if they did) to this point? Or, how are your ideas changing (if they are)?
Incrementally and tangentially. My reading of Anna Lowenhaupt Tsing’s treatise on the intricate relationships of the Matsutake mushroom (Lowenhaupt Tsing, Anna. The Mushroom at the End of the World: on the possibility of life in capitalist ruins. Princeton: Princeton University Press, 2015.) has lead to my consideration of cracked earth as a wound, and to look to the process of kintsugi as a potential ‘healing’.
I have been considering bacteria, mould and fungal systems as generative entities in their own right, and allowing my current themes to take on board a more ecological, sustainably-aware stand point which makes my art practice more topical and therefore have greater resonance and relevance in present-day society.
- Has anyone done this kind of work in the past?
Many artists are or have been commentators on the issues presented by museological practices, life and still life, and the questions of worth and value. Among others:
Marc Quinn
His genomic portrait Sir John Sulston, 2001 was the first entirely conceptual portrait to be acquired by The National Portrait Gallery, London.
Andy Goldsworthy
Site-specific temporal collaborations with nature, notably soil, clay and ice.
Jake and Dinos Chapman
One day you will no longer be loved (that it should come to this) III, 2011
Defacing anonymous 19th century portraits to comment on mortality and contemporary societal attitudes.
Dieter Roth
Early exponent of biodegradable art, comprising of rotting foodstuffs with entomological interventions.
- Does anyone else do it now? Who are the artists that occupy this terrain?
Among others:
Dane Mitchell
In particular, Dust Archive 2003 – 2019.
One of the consequences of conceptual art is that often there is no tangible artefact, nothing to collect dust. Dust is surely the metaphorical summation of the whole museum ethic. It is the all-pervasive silent coloniser. It implies history, age, sacrosanctity and the eventual break down of all matter; the deterioration despite preservation and thus the universal temporality of all things.
Rachel Chapman
A British artist working alongside environmental mycologist Jane Nicklin cultivating bacterial samples from spores trapped in clothing which map their ecological and topographical journeys, revealing the intwined relationships between weather patterns, landscape and human intrusion.
Yusuke Asai
A Japanese artist who paints murals with different shades of locally sourced soil as a ‘living’ medium.
Maarten Baas
In his ‘Smoke’ series, the dutch designer burns antique chairs and ‘mends’ them with epoxy resin.
Yeesookyung
Her ‘Translated Vases’ are sculptural assemblages built from discarded crockery, epoxy and gold leaf.
- Who are the writers on these subjects? What specifically have they said, which motivates your own thinking for your work potentially?
My current reading list includes:
Petry, Michael. The Art of not making: The new artist/artisan relationship. London: Thames & Hudson Ltd, 2012
An exploration of the often overlooked collaborations between artist and artisan, where the named artist is the author but not the constructor of the resultant art piece.
Lowenhaupt Tsing, Anna. The Mushroom at the End of the World: on the possibility of life in capitalist ruins. Princeton: Princeton University Press, 2015.
Following the global migration and colonisation of the Japanese delicacy – the matsutake mushroom – a capitalist commodity and a symbol of diasporic freedoms.
De Souza, Allan. How Art Can Be Thought: A Handbook for Change. Durham: Duke University Press, 2018.
Park, Geoff. Nga Uruora: The groves of life – ecology and history in a New Zealand landscape. Wellington: Victoria University Press, 1995.
- Is your field an established one or do you have to invent it? What histories are you contributing to?
History is the propaganda of the conquering side; a partisan, imperialistically imposed perspective; a colonial artefact in its own right. After generations of systematic command and privilege, the hegemonic authority of the museum construct has at last been challenged. Observe the Auckland City Museum, a war memorial no less; a western Neoclassical structure epitomising western cultural idealism. This edifice supplants the site of an historic Maori Pa, displaying Maori taonga to Western tourists. How colonial is that? Dominant cultures have chosen to quantify, preserve, value and tell the interconnecting histories of mankind and our environment.
To this forum, I bring an examination of the methodic and compelling need to classify this world of ours, to conquer our domain, to control the lifeforms within and the span and quality of their existence.
I am aware of my station as a foreign import, a neo-colonial even. I am a non-native; a British artefact out of context, so it is perhaps appropriate that my work addresses these themes.
